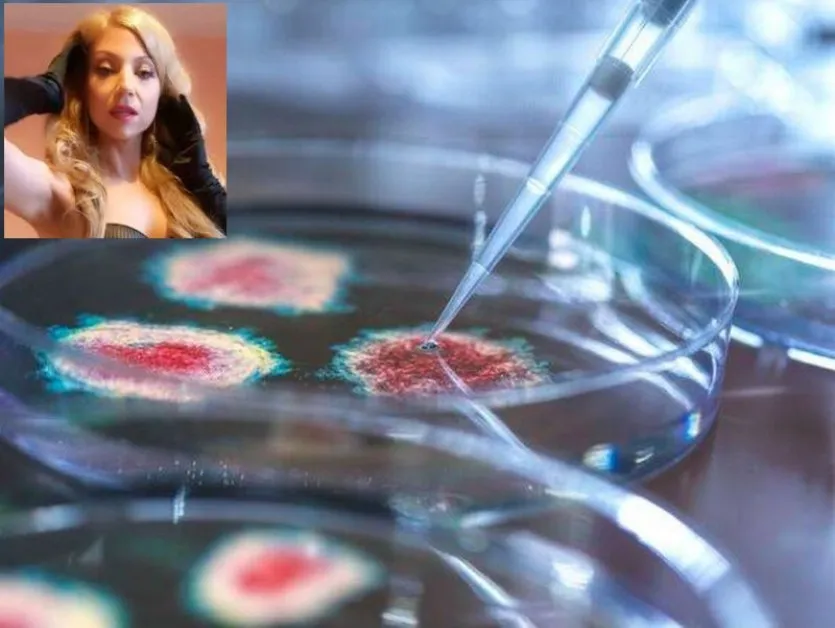

Британската медиумка Селина Авалон предупреди за потенциална епидемия от смъртоносна болест, която може да се превърне в глобална здравна криза за по-малко от пет години. Медиумката направи и редица прогнози относно геополитиката, технологиите и обществените промени през 2026 г.
Според британския таблоид The Mirror, жената е написала в блога си през октомври, че следващите години могат да бъдат период на значителни предизвикателства за човечеството. Тя твърди, че на африканския континент може да се появи ново „чумоподобно“ заболяване, което да представлява сериозна заплаха за глобалното здраве. Екстрасенсът го описва като „нов щам на смъртоносна бактерия или вирус“, чийто мащаб на последиците тя оценява като катастрофални.
„Виждам нещо, което прилича на много голяма чума, зараждаща се на африканския континент“, отбеляза тя.
Екстрасенката не уточни колко широко може да се разпространи болестта географски извън континента, въпреки че формулировката ѝ предполага сериозна заплаха за здравето в световен мащаб - но не направи паралели със скорошни пандемии, преживяло човечеството.
В допълнение към потенциална пандемия, ясновидката направи редица други прогнози за 2026 г. Те включваха мащабни кибератаки и прекъсвания на електрозахранването във Великобритания, смъртта на виден световен лидер с държавно погребение, нарастващото влияние на изкуствения интелект при изпълнението на човешки задачи, ескалацията на съществуващите международни конфликти и развитието на авиационните технологии.
 Гадателка "видя" смъртта на един от световните лидери през 2026 г.
Гадателка "видя" смъртта на един от световните лидери през 2026 г.
В същото време някои от нейните прогнози може да се сбъднат не през 2026 г., а в рамките на следващите 5-10 години.
Коя е Селина Авалон?
Общоизвестно е, че Селина Авалон управлява платформата SoulVoyance и редовно провежда онлайн обучения. Освен това, тя комбинира психически четения с астрологически и мистичен анализ. Тя споделя своите прозрения, особено когато са свързани с глобални или хуманитарни проблеми, които могат да засегнат обществото.
Ясновидката редовно споделя своите предсказания чрез видеоклипове, подкасти и социални медии, отбелязвайки, че целта ѝ е да предупреждава хората за потенциални заплахи и важни глобални събития.
Прочетете още
- 19:00 Как се продават новите жилища? Откраднато е над 1 млрд. евро ДДС само в София и Пловдив ВИДЕО
- 08:26 Стана ясно кой е младежът, убит заради 40 евро на Лъвов мост
- 21:06 Нападнаха екип на GlasNews по време на репортаж край "Лъвов мост", има задържани СНИМКИ
- 23:00 Дневен хороскоп за 23 юни: Близнаци, любовта е във въздуха - уловете я!